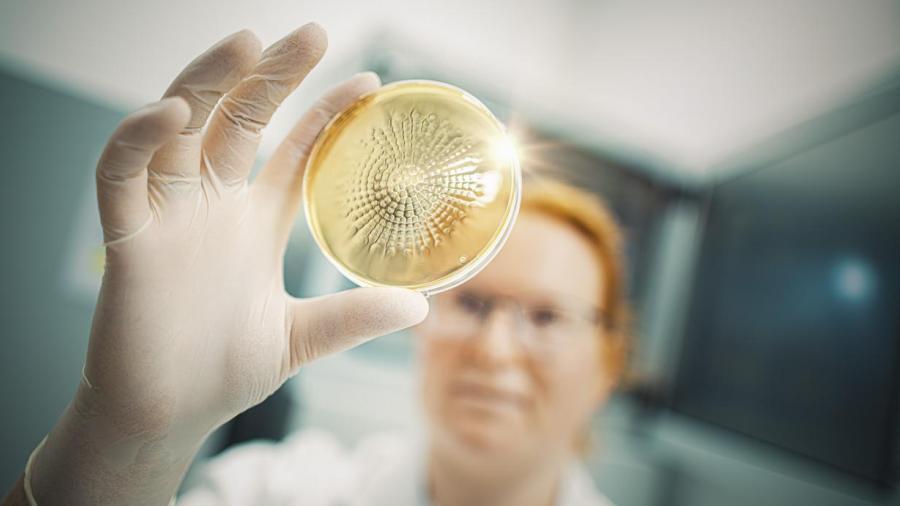

Our viable environmental monitoring laboratories
As leading provider in the radiopharmaceutical industry, we understand the critical importance of maintaining a clean and safe environment in our manufacturing clean rooms. That's why we've invested heavily in our environmental monitoring capabilities, ensuring that our clean rooms meet the requirements of EU GMP Annex 1, ISO, and USP standards.
Our state-of-the-art environmental monitoring systems allow us to continuously monitor key parameters such as air quality, temperature, humidity, and pressure differentials, ensuring that our clean rooms maintain a stable and controlled environment at all times. Our staff conduct regular tests and analyses, using the latest technology and methodologies to detect and mitigate any potential risks to product quality.
At every step of the process, we strive for excellence in compliance, documentation, and reporting. Our data management systems ensure that all environmental monitoring data is tracked, recorded, and reported in accordance with regulatory requirements, providing full traceability and transparency for our own quality assurance teams, as well as for regulatory agencies if required.
Viable environmental monitoring in cleanrooms is:
| Sampling (Active Air, Passive Air, Surface Sampling, and SWAB) |
| Incubation of samples for various time frames and temperatures |
| Evaluation of microbiological samples |
| Trending and statistical analyses of microbiological data |
·Contact us today to learn more about our viable environmental monitoring approach!